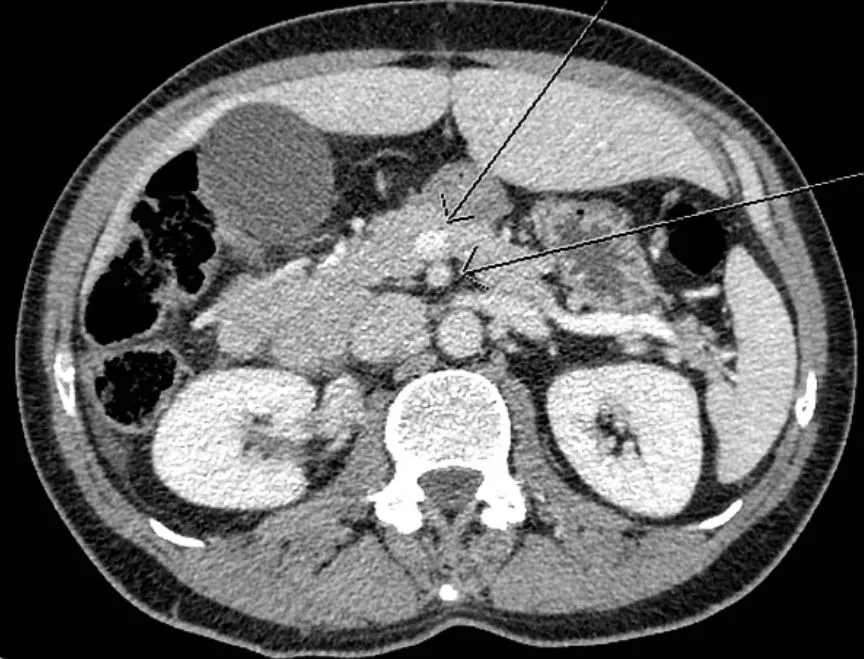

슬기로운 의사생활의 슬기로운 리뷰 #1
1. CPR 장면 (2'40'' ~ 4'10'')

CPR은 심정지가 온 사람을 살릴 수 있는 가장 중요한 방법이다.
CPR은 Cardio-pulmonary resuscitation의 약자로 철자 그대로 심장이 멎었거나, 호흡을 하지 못하는 사람에게 행하는 응급처치이다.
심장이 뛰지 못하면 혈액을 통해 산소와 영양소를 공급해주지 못하기 때문에 장기 손상이 일어나게 된다. 그 중 가장 취약한 것은 뇌로 심장이 멎은 상태로 10분이 지나게 되면 돌이킬 수 없는 손상을 입기 때문에 설사 이후 심장이 다시 뛰게 된다고 해도 정상적인 생활을 할 수 없게 된다.
최근엔 교육이 많이 되고 있는 것 같고 필자와 같은 의료진은 1년에 1번 정도는 교육을 받게된다.
(물론, 의료진의 CPR 교육은 좀 더 복잡하다. 2주 후에 교육 받아야 하는데 으어어...)
의학드라마의 분위기를 긴박하게 할 수 있는 아주 좋은 소재였다고 생각한다. 이 장면에서 나름 흡족(?)하게 봤던 장면과 좀 불편했던 장면을 서술하자면 아래와 같다.
Bad

보통 CPR 현장에 2명이 있으면 한명은 흉부압박을, 다른 사람은 호흡 및 제새동기를 담당한다.
이 때 호흡 유지를 위해 턱을 젖히는 과정에서 의사라면 보통 3~5째 손가락을 턱에두고 엄지와 검지는 C자 모양으로 입을 감싸는 듯한 손동작을 취하게 된다. 드라마에선 턱을 잡기 급급한 모습이던데, 산부인과 의사라면 나름 Vital을 보는 과인데 너무 일반인처럼 그려놓은게 아닌가 싶었다.
 운동안하고 기름진 음식 먹으면 이렇게 혈관이 막힙니다
운동안하고 기름진 음식 먹으면 이렇게 혈관이 막힙니다CPR 초기 과정에서 중요한 것은 호흡과 맥박이 정상인지 확인하는 것이다.
보통 호흡은 얼굴과 흉곽의 확장 여부를 동시에 확인하고, 맥박은 Carotid artery를 통해 확인한다.
이 글을 보시는 분들도 잠시 손을 목에 가져다대면 박동을 느낄 수 있을텐데, 얘가 Carotid artery이고 머리를 먹여 살리는 동맥이라고 생각하면 이해하기 쉬울 것이다.
맥박이 정상인지 알기 위해선 적어도 3~4초 정돈 여길 대봐야 한다. 불규칙하게 뛸 수도 있고, 미약하게 뛰고 있을 수도 있으니깐. 그런데 드라마에선 픽하고 쓰러지니 목에 손을 갖다대고, 0.5초만에 맥박이 안뛴다고 하여 CPR로 넘어갔는데 이것을 신경외과 교수의 능력이라고 하면 할말은 없다만.. 보통 이렇게 허겁지겁 넘어가진 않는다.
참고로 양쪽의 carotid artery를 막아 뇌에 일시적 산소 공급을 중지시키는 것이 '기절놀이'이다.
Good
의사들은 무의시적으로 '환자'라고 표현하는 경우가 많다. CPR후 의식이 돌아온 기사분께 '환자'라고 하던데 물론 CPR 후 상태이므로 환자라고 할 수도 있겠지만 개인적으론 습관적으로 '환자'라고 부르던 것이 튀어나온 것이 아닐까 싶다. 흠.. 뭔가 써보니 너무 억지스럽긴 하지만 필자가 그렇게 느꼈으면 그런거죠...
2. 소아과 외래(6'20''~8')
소아과를 지원하려던 수많은 동기들을 포기하게 만들고, 현 소아과 수련하고 있는 동기들을 스트레스 받게 만드는 가장 큰 요인은 보호자이다. 자식이 아프면 신경쓰이는 것을 누가 이해 못하겠냐만 가끔 필요 이상의 반응 때문에 의료진을 힘들게 만드는데 그 모습이 너무 잘 표현되어 있어 마음에 들었다.
CT판독은 저도 잘 못합니다... 장이 꼬였대요
CT판독은 저도 잘 못합니다... 장이 꼬였대요외래에서 갈등의 요소가 된 것 중에 하나가 수술을 해야하나 말아야 하나 때문인데, 아마 이 상황은 아이의 장이 꼬여서 괴사가 진행된 경우인 듯 하다.
보통 장이 꼬여도 저절로 풀리는 경우가 많아서 괴사가 진행되지 않으면 기다려볼 수 있겠으나 이미 괴사가 진행됐다면 수술을 해야한다. 안 그러면 터진다...
소아의 경우 처치가 복잡한 경우가 많은데, 인터넷엔 이렇다더라 하면서 의사의 조언을 듣지 않으면... 참 의사노릇 하기 싫어진다.
3. 사랑의 매(8'20''~9')
필자가 이 드라마를 가장 마음에 들어했던 이유다. 역시 수련의는 교수에게 까여야 제맛!
특히나 흉부외과면 인력도 부족할테니 한명이 담당하는 환자 수도 많을테고.. 그러면 잘 쉬질 못하니 피곤해지고, 피곤하면 환자를 더 못 보고, 그럼 더 까이고..
"뭐해 빨리 않오고" 마지막 대사까지 훌륭했습니다. 10점 만점에 10점 드리겠습니다.
참고로 외과 의사들이 입고 있는 옷은 대개 당직복/수술복에 가운인 경우가 많다. 신발은 크록스
4. 중환자실 보호자(26'~29')
가끔 중환자실에서 일하다보면 장기입원 중인 분이 있다.
그 중에서도 유독 소아 환자가 있는데, 그럼 정말 하루도 빼놓지 않으시고 보호자 분들께서 찾아오신다.
그 모습을 보면 참 가슴이 먹먹해진다.
그렇게 오래 왔다갔다 하시다보면 정말 왠만한 의사 뺨치게 약에 대해 잘 알게 되신다.
다만 매번 말하지만 술기를 하는 것은 보통 간호사 아니면 인턴이다. 오더를 넣는 것은 주치의, 즉 레지던트이고. 즉, 왜 이 약이 빠졌는지 술기를 하고 있는 사람한테 물어봐도 알 수 없다는 것이다.
한편, 한쪽에선 CPR이 일어나고 있지만 한 쪽에선 졸고 있는 장면도 참 공감이 갔다. 사람의 생명을 살리는 존재가 어떻게 사람의 생명이 꺼져가는데 그렇게 무덤덤할 수 있냐고 물어볼 수 있겠다. 하지만, 오히려 죽음에 가장 가까이 있기에 가장 무감각해지는 존재가 의사이다. 그렇게하지 않으면 살아남을 수 없으니깐. 그래서 필자는 의학드라마에서 사람이 죽는 것에 울부짖는 캐릭터를 보면 갑자기 몰입이 되지 않는다. 물론 나중에 퇴근하고 술 한잔 했을 때 힘들다고 털어놓을 순 있겠지만, 병원 안에서 그러는 것은 아무에게도 도움이 되지 않는다.
아, 그런데 중환자실 들어가는데 마스크도 안하고 있는건 좀 너무하지 않나... 불편합니다 드라마 작가님
5. 간이식 수술(37'20''~38')
간이식 수술은 우리나라에서 제일 비싼 수술이다. 즉, 제일 힘들고 가장 인력이 많이 들어가는 수술이다.
수술이라고하면 교수 1명이서 뚝딱하는 걸로 생각하는데, 절대로 그렇지 않다. 수술장 간호사도 있고, 보조해주는 펠로우 및 수련의도 있다. 이들이 다같이 협심해야 한다. 그런데 수술이라는 것이 교수마다 스타일이 다르고, 쓰는 도구도 조금씩 다르다. 이것을 외부에서 온 사람과 손 맞춰 진행한다? 일단 다른 병원에 속해있는 의사가 수술을 집도한다는 것부터 의료법 위반일 것 같은데.
가장 현실적인 시나리오는 해당 병원에 수술할 여건이 되지 않는다고 판단되는 즉시 간이 필요한 다른 사람에게 넘어가는 것이다. 수술이 잘못돼서 그 간이 손상된다면 애타게 기다리고 있을 다른 환자들은 무슨 잘못이란 말인가. 그리고 머리에 저런걸 달고 수술방을 들어간다니. 참, 의료인으로서 어이가 없었다. 그러다 감염되면 다시 배 갈라야 할텐데?
음 갑자기 감정이 너무 격해진것 같군요. Relax
그 외에 당직실에서 생활하는 신경외과 의사의 삶이라든지 의예과 학생들의 장기자랑 모습이라든지 소소하게 공감되는 포인트가 많아서 다음 화가 벌써부터 기대가 된다.
참고로, 소아외과 의사는 외과의사입니다~